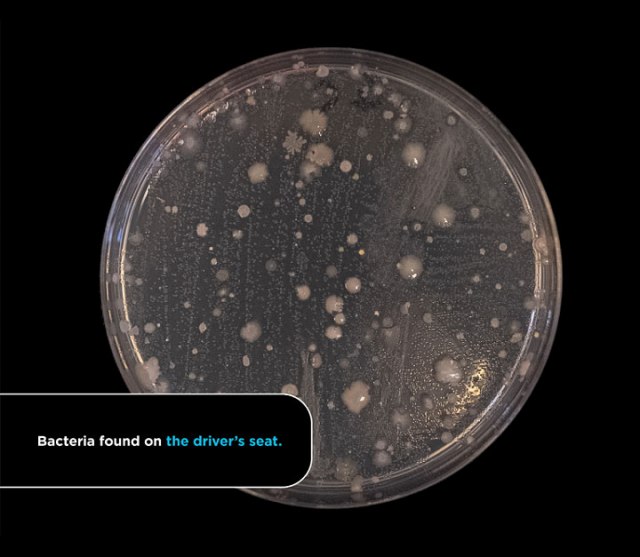

Prvi pogled često vara, a u slučaju enterijera automobila najvažniji je onaj drugi iza kojeg stoje ozbiljni stručnjaci.
Iako možda kabina vozila deluje korektno, odnosno relativno čisto, najvažnije je ono što ne možete videti golim okom. To je svet bakterija, od kojih vam neke mogu uzrokovati i posetu lekaru, piše Revijahak.
Scrap Car Comparison sproveo je istraživanje u Velikoj Britaniji, koje je podrazumevalo uzimanje uzorka iz dva WC-a i pet vozila. Ispostavilo se da je svako od testiranih vozila sadržavalo fekalne bakterije.

Pomalo iznenađujuće, najveća koncentracija fekalnih bakterija pronađena je u prtljažniku, tamo gde često prevozimo namirnice, koje zatim stavljamo na radnu površinu kuhinje.
Fekalne bakterije odomaćile su se u znatnoj meri i na vozačevom sedištu, što je malo manje iznenađujuće.
Što se tiče najprljavijih mesta u automobilima, prtljažnik je osvojio zlatnju medalju i uverljivu prvu poziciju jer je tamo pronađeno 1.425 bakterija. Zatim slede vozačevo sedište (649 bakterija), ručica menjača (407 bakterija), zadnje sedište (323 bakterije) i komandna tabla (317 bakterija).
Jedno od najčistijih područja u automobilima je upravljač što je iznenađujuće jer vozači drže ruke na volanu, ali naučnici veruju da bi se to moglo objasniti povećanom upotrebom sredstava za dezinfekciju ruku tokom pandemije koronavirusa.
Na malom uzorku pokazalo se da starija vozila imaju više bakterija. Svaki je automobil takođe sadržavao značajno veću ukupnu količinu bakterija nego svaki uzorkovani WC.
Autor studije dr Džonatan Koks objašnjava:
“Uzorkovani automobili bili su veoma kontaminirani, i to ne samo bakterijama koje bismo očekivali u vozilu, kao što je stafilokoka epidermidis, vrstom kožnog mikroba koji se nalazi na rukama. Pronašli smo ešerihiju koli u nekim delovima automobila, kao što je prtljažnik, koja je vrsta fekalne bakterije i može uzrokovati trovanje hranom, proliv i povraćanje ako se proguta u značajnoj količini.”

“Međutim, da bismo identifikovali rizike od pronađenih bakterija, morali bismo stvarno ući dublje u mikrobiologiju kako bismo razumeli svaku vrstu. Ljudi se, naravno, ne razboljevaju svaki put kad uđu u auto. Ne treba da budemo preterano zabrinuti, samo treba imati na umu da nije sva prljavština vidljiva golim okom”, kaže dr Koks.
“Ova studija je pokazala da bi ljudi definitivno mogli da se više potrude da svoj automobil održe čistim. Na kraju krajeva, radi se o smanjenju rizika od bolesti. Malo je verovatno da ćemo jesti hranu u prtljažniku našeg automobila, ali često konzumiramo hranu na vozačevom sedištu. Zato je dobra odluka da očistimo ruke pre nego što krenemo da jedemo u tom okruženju. Saznanje o tome gde se mogu nalaziti mikroorganizmi može nam pomoći da razmišljamo više o svojim navikama dok vozimo”, zaključuje on.
B92.






























